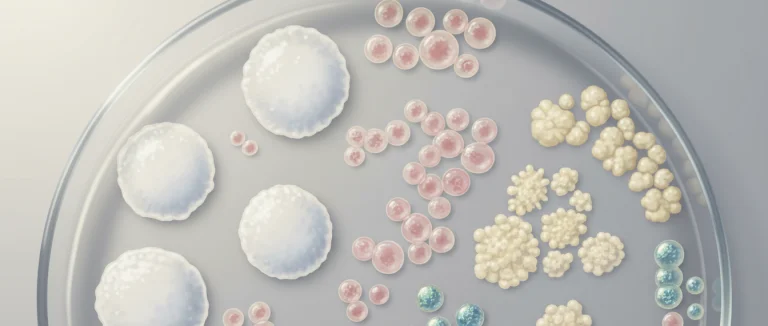
Посев мочи в лаборатории

Бактерии в моче: что означают результаты анализа УТИ
-
Что означает наличие бактерий в анализе мочи?
-
Как проводится анализ мочи и как интерпретировать результаты?
-
Какие симптомы могут указывать на инфекцию мочевых путей?
-
Методы диагностики и лечения инфекций мочевых путей
-
Профилактика и когда обращаться к врачу
-
Почему выбирают Лив Хоспитал
Наличие бактерий в анализе мочи часто вызывает тревогу у пациентов, особенно у тех, кто впервые сталкивается с результатами лаборатории. Этот показатель может указывать как на простую бактериальную контаминацию образца, так и на серьезную инфекцию мочевых путей (УТИ). В статье мы разберём, какие причины могут стоять за обнаружением бактерий, как правильно интерпретировать результаты и какие шаги предпринять дальше.
По данным Всемирной организации здравоохранения, более 150 миллионов человек ежегодно сталкиваются с УТИ, и большинство из них обнаруживают проблему именно через анализ мочи. Правильное понимание результатов помогает избежать ненужных тревог и своевременно начать лечение.
Мы расскажем о типичных симптомах, методах диагностики, современных подходах к лечению и профилактике инфекций, а также о том, как Лив Хоспитал обеспечивает комплексный подход к каждому пациенту.
Что означает наличие бактерий в анализе мочи?
Обнаружение бактерий в анализе мочи может иметь несколько интерпретаций. Важно учитывать количество бактерий, наличие сопутствующих показателей и клиническую картину пациента.
- Контаминация образца – часто происходит при неправильном сборе мочи, особенно у женщин, где бактерии из вагинальной флоры могут попасть в пробу.
- Бактериальная инфекция – если количество бактерий превышает пороговое значение (обычно >10⁴ КОЕ/мл), это свидетельствует о настоящей инфекции мочевых путей.
- Ассимптоматический бактериурия – наличие бактерий без явных симптомов, часто обнаруживается у пожилых пациентов или при обследовании перед операцией.
Для точного диагноза лаборатория обычно измеряет также лейкоцитарный эстераз и количество лейкоцитов (пирурия). Повышенный уровень этих маркеров вместе с бактериями усиливает вероятность инфекции.

Как проводится анализ мочи и как интерпретировать результаты?
Стандартный анализ мочи включает макроскопическое, микроскопическое и биохимическое исследование. При подозрении на инфекцию врач обычно назначает посев мочи, который позволяет точно определить вид бактерий и их чувствительность к антибиотикам.
| Показатель | Нормальное значение | Патологическое значение |
|---|---|---|
| Бактерии (колония) | Отсутствует | >10⁴ КОЕ/мл |
| Лейкоциты (пирурия) | 0–5/мкл | >10/мкл |
| Лейкоцитарный эстераз | Отрицательно | Положительно |
| Эритроциты | 0–3/мкл | >5/мкл |
Если в результате посева обнаружены Escherichia coli (E. coli) – самый частый возбудитель УТИ, врач подбирает антибиотик, учитывая результаты теста чувствительности. При отсутствии роста бактерий, но присутствии лейкоцитов, возможен нелаймовый процесс, требующий дополнительного обследования.
Какие симптомы могут указывать на инфекцию мочевых путей?
Симптомы УТИ могут различаться у мужчин и женщин, но основные признаки обычно включают:
- Жжение или боль при мочеиспускании.
- Частое позывы к мочеиспусканию, иногда с небольшим объёмом мочи.
- Боль внизу живота или в поясничной области (симптомы почечной инфекции).
- Помутнение или неприятный запах мочи.
- Повышенная температура, озноб (при распространении инфекции на почки).
У женщин часто появляются дополнительные признаки, такие как болезненность в области таза, а у мужчин – боль в простате или уретре. При появлении этих симптомов рекомендуется как можно быстрее сдать анализ мочи, чтобы исключить развитие более тяжёлой формы инфекции.

Методы диагностики и лечения инфекций мочевых путей
Помимо стандартного анализа и посева, в сложных случаях используют дополнительные методы:
- УЗИ почек и мочевого пузыря – помогает выявить обструкцию или наличие камней.
- КТ или МРТ – применяются при подозрении на осложнённую инфекцию, например, абсцесс почки.
- Цитологический анализ мочи – используется для исключения онкологических процессов.
Лечение обычно начинается с назначения антибиотиков, выбранных на основе чувствительности выявленного штамма. Часто применяются препараты из групп фторхинолонов, цефалоспоринов или нитрофуранов. При аллергии или резистентности могут использоваться альтернативные схемы, такие как амоксициллин/клавулановая кислота.
Важно завершить курс антибиотиков полностью, даже если симптомы исчезли, чтобы предотвратить рецидив и развитие резистентных штаммов. При тяжёлой почечной инфекции (пиелонефрит) иногда требуется госпитализация и внутривенное введение препаратов.
Профилактика и когда обращаться к врачу
Профилактика УТИ включает простые, но эффективные меры:
- Поддержание адекватного уровня гидратации – не менее 2 литров воды в день.
- Регулярное опорожнение мочевого пузыря, особенно после полового акта.
- Избегание задержки мочи и длительного ношения тесного белья.
- Приём пробиотиков для поддержания здоровой микрофлоры.
- Контроль за уровнем сахара у пациентов с диабетом.
Обратиться к врачу следует, если наблюдаются любые из перечисленных симптомов более 24 часов, при повышенной температуре, крови в моче или при повторных эпизодах инфекции. Своевременное обследование позволит избежать осложнений, таких как абсцесс почки или хронический цистит.
Почему выбирают Лив Хоспитал
Лив Хоспитал – аккредитованная JCI группа больниц в Стамбуле, специализирующаяся на обслуживании иностранных пациентов. Мы предлагаем комплексный подход к диагностике и лечению инфекций мочевых путей: от первичного анализа до высокоточных методов визуализации и индивидуального подбора антибиотиков. Наши международные координаторы помогают с записью, переводом и организацией проживания, обеспечивая комфорт и безопасность на каждом этапе лечения.
Если вы обнаружили бактерии в анализе мочи или заметили симптомы УТИ, запишитесь на консультацию в Лив Хоспитал уже сегодня. Наши эксперты быстро оценят результаты, подберут эффективное лечение и обеспечат полную поддержку во время вашего пребывания в Стамбуле.
Часто задаваемые вопросы
Наличие бактерий в моче может свидетельствовать о нескольких состояниях. При неправильном сборе мочи часто происходит контаминация, особенно у женщин, когда бактерии из вагинальной флоры попадают в пробу. Если количество бактерий превышает порог >10⁴ КОЕ/мл и сопровождается повышенным уровнем лейкоцитов и лейкоцитарного эстераза, это указывает на настоящую инфекцию мочевых путей. Кроме того, существует асимптоматическая бактериурия – наличие бактерий без клинических проявлений, часто у пожилых пациентов.
Контаминацию обычно характеризует небольшое количество бактерий и отсутствие лейкоцитов, а также отсутствие симптомов. При настоящей инфекции количество бактерий превышает 10⁴ КОЕ/мл, наблюдается пиурия (повышенный уровень лейкоцитов) и положительный лейкоцитарный эстераз. Кроме того, у пациента появляются типичные симптомы УТИ – жжение при мочеиспускании, частые позывы, боль внизу живота и т.д. Для уточнения часто назначают посев мочи, который определяет вид бактерий и их чувствительность к антибиотикам.
Классические симптомы УТИ включают жжение или боль при мочеиспускании, учащённые позывы к мочеиспусканию с небольшим объёмом, боль в нижней части живота или поясничную боль при поражении почек, помутнение или неприятный запах мочи, а также субфебрильную температуру и озноб при распространении инфекции. У женщин могут появляться боли в области таза, у мужчин – боль в простате или уретре. При появлении этих признаков рекомендуется немедленно сдать анализ мочи.
После подозрения на УТИ врач назначает посев мочи. Образец помещают на питательную среду и инкубируют, что позволяет вырастить колонии бактерий. Затем микробиолог определяет вид возбудителя (например, Escherichia coli) и проводит тесты чувствительности к различным антибиотикам. Это помогает подобрать оптимальную схему лечения, избежать неэффективных препаратов и снизить риск развития резистентности.
Лечение УТИ начинается с подбора антибиотика, учитывая чувствительность выявленного штамма. Чаще используют фторхинолоны, цефалоспорины или нитрофураны. При аллергии или резистентности могут применяться амоксициллин/клавулановая кислота или другие альтернативные препараты. Курс антибиотиков следует завершать полностью, даже если симптомы исчезли, чтобы предотвратить рецидив. При осложнённых формах, таких как пиелонефрит, может потребоваться госпитализация и внутривенное введение препаратов, а также визуализационные исследования (УЗИ, КТ).
Профилактика включает пить достаточное количество воды (не менее 2 литров в день), не задерживать мочеиспускание, особенно после полового акта, носить свободное бельё, принимать пробиотики для поддержания здоровой микрофлоры, контролировать уровень сахара у пациентов с диабетом и при необходимости использовать профилактические препараты. Эти меры снижают вероятность бактериальной колонизации и последующего развития инфекции.
* Содержимое нашего сайта предназначено только для информационных целей. Обязательно обратитесь к врачу для диагностики и лечения. В содержание страницы не включены элементы, содержащие информацию о терапевтических медицинских услугах в Лив Госпитале.